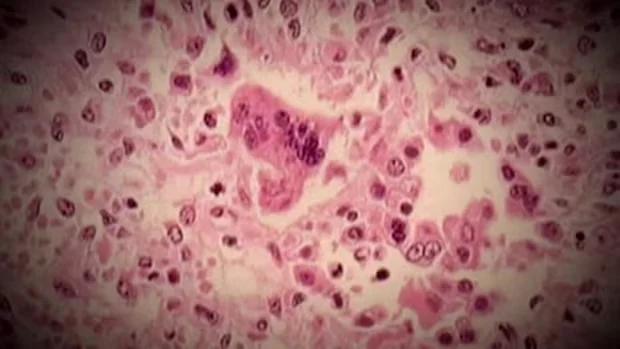

Canada Loses Measles-Free Status
Canada has lost its measles-free status due to declining vaccination rates. This decrease has sparked concerns about potential outbreaks across the nation. Many factors have contributed to this alarming trend, particularly during the COVID-19 pandemic when vaccination efforts faced significant setbacks.
Vaccination Rates Plummet
Measles is an exceptionally contagious disease. The World Health Organization has emphasized that vaccination rates need to reach at least 95% to prevent transmission. However, Canada has experienced troubling declines.
Statistics on Vaccine Uptake
- First Dose Coverage: Fell from approximately 90% in 2019 to 83% in 2023.
- Second Dose Coverage: Decreased from about 86% to 76% during the same period.
The Public Health Agency of Canada released these figures showing a significant downward trend in vaccination rates.
Regional Disparities in Vaccination
Some communities face dire circumstances. In Quebec, certain schools in the Montreal area reported vaccination rates as low as 30%. Other areas have also struggled.
- Some schools in Montreal: Vaccination rates between 30% and 50%.
- Alberta: Reported rates as low as 29% to 40% in specific regions.
Implications of Lower Vaccination Rates
As vaccination rates decline, the risk of measles outbreaks increases dramatically. The disease spreads rapidly in under-vaccinated communities. Public health officials warn that without intervention, these localities may experience significant public health threats.
Enhancing vaccination efforts is crucial. Increased awareness and community engagement can help restore public confidence in vaccines. Canada must prioritize these initiatives to regain its measles-free status.



